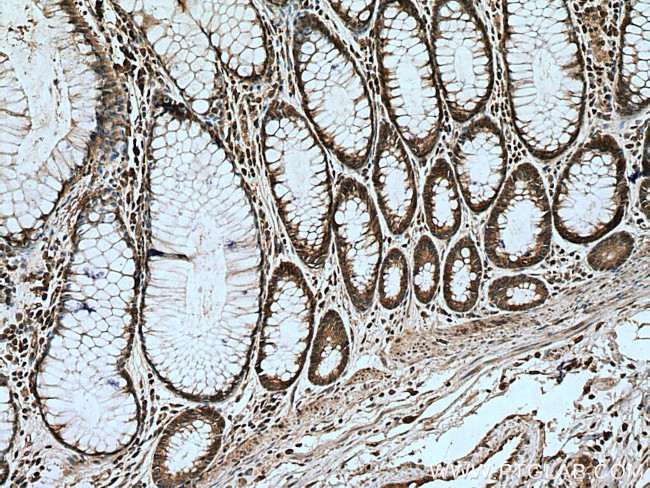
RUNDC1 Antibody in Immunohistochemistry (Paraffin) (IHC (P))

Search
Proteintech
RUNDC1 Polyclonal Antibody
{{$productOrderCtrl.translations['antibody.pdp.commerceCard.promotion.promotions']}}
{{$productOrderCtrl.translations['antibody.pdp.commerceCard.promotion.viewpromo']}}
{{$productOrderCtrl.translations['antibody.pdp.commerceCard.promotion.promocode']}}: {{promo.promoCode}} {{promo.promoTitle}} {{promo.promoDescription}}. {{$productOrderCtrl.translations['antibody.pdp.commerceCard.promotion.learnmore']}}
产品信息
17267-1-AP
种属反应
宿主/亚型
分类
类型
抗原
偶联物
形式
浓度
规格
纯化类型
保存液
内含物
保存条件
运输条件
产品详细信息
Immunogen sequence: EQLVEQLKT QIRDLEMFIN FIQDEVGSPL QTGGGHCECK AGGKTGNGCS RTGSSRTPPG NSKTKAEDVK KVRETGLHLM RRALAVLQIF AVSQFGCATG QIPPTLWQRV QADRDYSPLL KRLEVSVDRV KQLAMRQQPH DHVITSANLQ DLSLGGKDEL TMAVRKELTV AVRDLLAHGL YASSPGMSLV MAPIACLLPA FSSAPEAMHP WELFVKYYHA KNGRAYVESP ARKLSQSFAL PVTGGTVVTP KQSLLTAIHM VLTEHDPFKR SADSELKALV CMALNEQRLV SWVNLICKSG SLIEPHYQPW SYMAHTGFES ALNLLSRLSS LKFSLPVDLA VRQLKNIKDA F (264-613 aa encoded by BC039247)
靶标信息
RUNDC1 may play a role as p53/TP53 inhibitor and thus may have oncogenic activity.
仅用于科研。不用于诊断过程。未经明确授权不得转售。
篇参考文献 (0)
生物信息学
蛋白别名: RUN domain containing 1; RUN domain-containing protein 1; unnamed protein product
基因别名: AW125546; D930024B17; LP5161; RUND1; RUNDC1
UniProt ID: (Human) Q96C34, (Mouse) Q0VDN7
Entrez Gene ID: (Human) 146923, (Mouse) 217201, (Rat) 303552